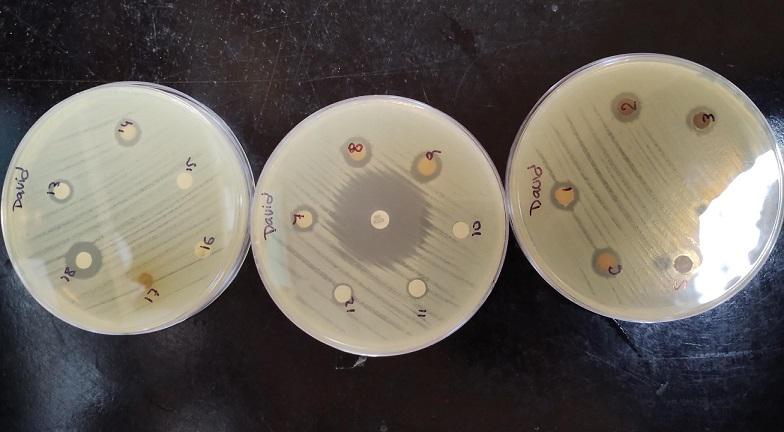
nanoparticulas-de-plata

Desde el 10 de noviembre se habilitarán en Chaco y Corrientes, postas de vacunación destinadas a completar los esquemas obligatorios de futuros estudiantes y personal universitario.

Desde el 10 de noviembre se habilitarán en Chaco y Corrientes, postas de vacunación destinadas a completar los esquemas obligatorios de futuros estudiantes y personal universitario.

Un becario de la UNNE, Sebastián Vargas analiza los cambios en el área central de Resistencia. La investigación es en el marco del proyecto de investigación sobre Políticas Urbanas del Área Metropolitana del Gran Resistencia (AMGR).

Un proyecto de la Facultad de Ciencias Veterinarias, a cargo de Mónica Pérez Gianeselli, anatomopatóloga analiza tejido cardíaco, para desarrollar una vacuna nasal para pacientes de chagas.

Estudiantes de la Facultad de Derecho y Ciencias Sociales de la UNNE realizan su aporte con análisis técnico, en las elecciones legislativas nacionales celebradas el domingo 26 de octubre.

Se trata de un espacio a cielo abierto proyectado por docentes investigadores de la Facultad de Ciencias Agrarias (FCA) de la UNNE Alli se enseña educación ambiental con un muestrario de especies nativas a cielo abierto.

Trabajo de investigación a cargo de becaria de la Secretaría de Ciencia y Técnica de la UNNE, podría servir para la formulación de políticas sanitarias del NEA, al identificar factores de riesgo hasta ahora desconocidos.

Para el aprovechamiento de los desechos agroindustriales, la Universidad Nacional del Nordeste (UNNE), Universidad Nacional de Santiago del Estero (UNSE) y el Centro de Referencia para Lactobacilos (CERELA-CONICET) logra el desarrollo de un aditivo alimenticio para peces elaborado a partir de cáscara de arroz y bagazo cervecero, inoculados con microorganismos.

Se está llevando adelante una investigación que podría beneficiar a quienes sufren de sensibilidad dental. Se trata de una formulación a base de propóleo, un elemento extraído de los apiarios de las colmenas de abejas.

Un trabajo de investigación a cargo de las doctoras Marina Judkevich; Paula Alayón Luaces y Ana María González investigadoras del Instituto de Botánica del Nordeste y de la UNNE, abren nuevas posibilidades para su cultivo.

En Campus Resistencia, se habilita una posta sanitaria para que quienes proyectan estudiar en la Universidad Nacional del Nordeste el año 2025, puedan actualizar sus carnets de vacunación.

El objetivo es dar información sobre las consecuencias del uso prolongado de dispositivos electrónicos entre universitarios, con foco en los síntomas del Síndrome Visual Informático.

Con talleres artísticos el Centro Cultural Universitario propone actividades abiertas al público del 27 al 29 de noviembre, desde las 18 horas en la Sala del Sol del CCU (Córdoba esquina 9 de julio), Corrientes.

Este 8 de Noviembre se conmemora en más de 30 países de cuatro continentes el Día Mundial del Urbanismo.Se trata de una jornada para reflexionar sobre cómo las ciudades pueden convertirse en espacios más inclusivos, resilientes y respetuosos del medio ambiente.

El Centro Cultural Nordeste ofrece una variedad de cursos y a precio accesible, en el caso de los alumnos regulares de la UNNE es gratuito, pero con cupos limitados.

Un estudio podría determinar cómo los cambios climáticos de las últimas décadas han modificado la forma de las lagunas en áreas periurbanas de Resistencia y Corrientes.

Ante la crítica situación en Corrientes, Chaco y Formosa el arquitecto Mario Berent propone una hoja de ruta para mejorar la gestión de residuos y promover el reciclaje en la región para el año 2030.

La iniciativa parte de un proyecto de extensión de la Facultad de Ciencias Exactas Naturales y Agrimensura de la UNNE. Busca mejorar la salud y el bienestar de las personas adultas mayores, a través de las tecnologías móviles.

Se realizará el lanzamiento del curso de Programación y Robótica, este martes 03 de septiembre, a las 9 horas en el Salón Elizondo del Campus Resistencia de la UNNE, Las Heras 727.

Se trata de la iniciativa “En camino hacia una alimentación saludable y nutritiva” está orientado a consolidar el compromiso de la Facultad de Ciencias Exactas y Naturales y Agrimensura de la UNNE con la realidad social, económica y cultural, desde una perspectiva territorial.
Un estudiante de la FaCENA de la UNNE utiliza plantas de la región, con un enfoque amigable con el medio ambiente, en el desarrollo de nanopartículas de plata con propiedades antimicrobianas.

La Universidad Nacional del Nordeste dicta un curso virtual sobre manejo de redes sociales, destinado a emprendedores, estudiantes y a cualquier persona interesada en aprender.

La doctora Claudia Mendoza médica asistencial en el Centro Nacional de Parasitología de la Universidad Nacional del Nordeste (UNNE) brindó recomendaciones a quienes sufren el contagio de dengue.

El Día Mundial de los Humedales se celebra cada 2 de febrero y en esta oportunidad la UNNE bajo el lema “Los Humedales y el bienestar humano” trata de generar conciencia sobre el cuidado de los ambientes y el cuidado de la tierra.

La Dirección de Recursos Naturales de Corrientes prohíbe la introducción, tránsito, comercialización y cultivo de la planta “lirio amarillo”, Iris pseudacorus L. (Iridaceae), una especie cuya problemática como invasora venía siendo estudiada a nivel país por investigadores de la UNNE y del Conicet.

Si bien el gobierno nacional señala que los usuarios ya inscriptos no deberán reinscribirse, abre la posibilidad de actualizar los datos.

La castración será de carácter gratuita y se realizará en dos jornadas, el martes 20 y el jueves 22 de enero, en el barrio La Liguria, ciudad de Resistencia.

Durante el período de vacaciones, miles de familias salen a la ruta o toman un avión junto a sus animales de compañía.

6 de cada 10 consumidores eligen dulces con fruta y los sabores ácidos crecen rumbo a 2026. Su incorporación en la pastelería se consolida como una tendencia global que combina salud, frescura y estética.S

Según Baufest este año estará marcado por la exigencia de rentabilidad, la redefinición de la ciberseguridad y el desafío de la visibilidad de marca en la era de los chat bots.

Son 24 localidades que se suman al programa Ruta de Carnavales 2026, que comenzará el viernes 23 de enero.

La artista argentina Gisela Martínez lleva el arte textil local a museos y tiendas de Estados Unidos, Europa, Israel y América Latina -y con Alemania sumándose a su red de exportaciones.

Madres con hijos con patologías graves reclaman al Insssep (Instituto de Seguridad Social,Seguros y Préstamos) la continuidad de los tratamientos médicos, en el Hospital Italiano.

Con motivo de celebrarse el 148° aniversario de la ciudad de Resistencia se realizarán diversas actividades culturales y artísticas en espacios emblemáticos.

Expediciones de Vinos propone viajes curados a regiones vitivinícolas de Europa y Argentina. Propone acceso a bodegas que no reciben público, grupos reducidos y experiencias irrepetibles, pensadas desde la relación directa con productores, enólogos y anfitriones.